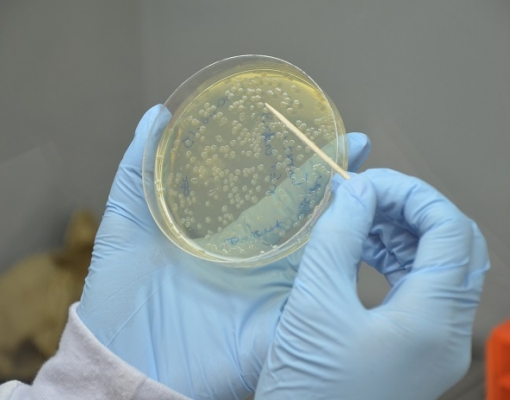

Pesquisadores desenvolvem microrganismos para retirar energia e produtos de biomassa
21-07-2017
Pesquisadores da Embrapa Agroenergia (DF) estão desenvolvendo tecnologia nacional para obter e transformar o que deve ser a matéria-prima mais utilizada na economia menos dependente do petróleo. Trata-se de açúcares contidos em folhas, caules, bagaços e outras partes de diferentes vegetais, a chamada biomassa. Para converter essa matéria-prima em combustíveis e vários produtos com origem renovável, o trabalho dos cientistas está centrado na engenharia genética de microrganismos que atuam como biofábricas. A equipe obteve material genético inédito de fungos e bactérias para utilizar com essa finalidade.
O primeiro desafio está em desconstruir a parede celular de vegetais para extrair açúcares, o que é feito com a utilização de um coquetel de enzimas, substâncias normalmente obtidas para uso comercial pelo cultivo de microrganismos. Atualmente, os poucos coquetéis disponíveis para essa desconstrução da biomassa são produzidos por multinacionais, com tecnologia importada. Nos laboratórios da Embrapa Agroenergia, porém, os cientistas já estão trabalhando com três fungos, obtidos por bioprospecção e engenharia genética, cujas enzimas alcançam rendimentos promissores do ponto de vista industrial.
Até o momento, foram cinco anos de pesquisa, que começou com a análise cuidadosa de materiais obtidos em bancos de microrganismos e amostras dos mais diversos ambientes – do solo da Amazônia ao rúmen de caprinos do Nordeste e intestinos de insetos da Argentina. Os pesquisadores buscavam fungos e bactérias capazes de produzir enzimas que digerem a celulose. Em alguns casos, não era possível cultivar os microrganismos para identificá-los. A equipe, então, utilizou técnicas avançadas de biologia molecular para acessar o DNA deles e descobrir genes que pudessem ser úteis, em um segundo momento, para o melhoramento genético das espécies mais promissoras.
E esse momento já chegou. Depois de uma experiência positiva utilizando genes patenteados por outras instituições, cientistas da Embrapa agora estão trabalhando com os materiais genéticos inéditos. “Desde o início, o objetivo era chegar a esse estágio; e conseguimos”, comemora Betania Ferraz Quirino, da Embrapa Agroenergia.
Transformando a xilose
Os coquetéis de enzimas extraem principalmente dois tipos de açúcares da biomassa: glicose e xilose. O primeiro é simplesmente adicionado aos tanques de fermentação das usinas e a levedura Saccharomyces cerevisiae o converte em etanol. Já a xilose tem uma estrutura química diferente, e esse microrganismo não consegue consumi-la para transformá-la em outros compostos.
Descartar a xilose, porém, está fora de cogitação. Esse é o segundo tipo de açúcar mais abundante na natureza – no bagaço de cana, por exemplo, equivale a 33% da biomassa. Por isso, ao mesmo tempo que trabalham no desenvolvimento de coquetéis de enzimas para desconstruir a biomassa, os cientistas buscam microrganismos capazes de converter a xilose em etanol – ou outros bioprodutos.
Na natureza, são inúmeros os seres que processam a xilose. O problema é encontrar um capaz de fazer isso e suportar um processo industrial, em condições específicas de temperatura e pressão. A solução é recorrer, mais uma vez, à engenharia genética. “Temos esse desafio: os microrganismos adaptados à indústria não são bons na metabolização da xilose, enquanto os que são bons em converter xilose não são tradicionalmente utilizados na indústria. Então, o que se tem que fazer é juntar essas duas partes: metabolismo de xilose e aplicação industrial”, detalha João Ricardo Moreira Almeida, da Embrapa Agroenergia.
O primeiro objetivo dos pesquisadores era obter linhagens que produzissem etanol a partir da xilose – e eles conseguiram. O rendimento ainda é baixo, mas os pesquisadores continuam trabalhando para otimizá-lo. No entanto, cada vez mais, eles têm se focado no uso desse açúcar para obter outros produtos, com maior valor de mercado do que o combustível. É o caso de ácidos orgânicos utilizados largamente nas indústrias químicas e de alimentos.
O futuro chegou
Utilizar açúcares em vez de petróleo e derivados para obter diferentes produtos é um futuro que já chegou. “O açúcar já começa a ser a base em diferentes processos biotecnológicos para produção de compostos químicos”, observa Almeida. E, com isso, o Brasil, grande produtor dessa commodity a baixo custo, atrai a atenção.
A Amyris, companhia de biotecnologia norte-americana, instalou em Brotas (SP), ao lado de uma usina de cana-de-açúcar, sua unidade de produção de uma molécula chamada farneseno. Uma vez convertida nesse composto por uma bactéria modificada geneticamente pela empresa, o açúcar da cana vira óleo e lubrificantes para motores e indústrias. A mesma estratégia foi adotada pela TerraVia, que em vez de bactérias utiliza microalgas. E, assim, a cana-de-açúcar se transforma em outros valiosos tipos de óleos, que já estão principalmente em cosméticos e devem chegar logo ao mercado de alimentos e rações.
Esses empreendimentos, contudo, valem-se do açúcar do caldo da cana. A expectativa, e o esforço da pesquisa, é para que a bioeconomia seja movida pelo açúcar da biomassa, contido na celulose e na hemicelulose da parede vegetal, hoje subaproveitado. “A celulose é o polímero mais abundante na natureza”, lembra Almeida. Qualquer cultura agrícola, produzida em qualquer condição climática, com a finalidade que for, tem folhas, caules e bagaço, dos quais se pode extrair açúcar.
Para o aproveitamento do material disponível no bagaço e na palhada da cana, surgiram até o momento duas unidades de produção de etanol no Brasil. A primeira, em Alagoas, começou a operar em setembro de 2014, mas suspendeu a produção em abril de 2016. À época, foi divulgado que a empresa vinha enfrentando problemas nas etapas iniciais do processo produtivo e que avaliaria outras tecnologias. A segunda unidade está em Piracicaba (SP).
Na avaliação de Almeida, a experiência desses primeiros empreendimentos tem mostrado que o processo de obtenção dos açúcares a partir da biomassa funciona e pode atingir bons rendimentos. Mas o escalonamento também começa a mostrar novos problemas para as equipes buscarem soluções. “Os grandes gargalos foram ultrapassados, mas o processo precisa ser otimizado em escala industrial”, resume.
O maior desafio para os centros nacionais de pesquisa é que todas essas empresas pioneiras operam principalmente com tecnologias trazidas de fora do Brasil. Para Almeida, desenvolver soluções nacionais é uma questão estratégica.
Saiba mais
Clique aqui e conheça ativos tecnológicos da Embrapa Agroenergia para aproveitamento de açúcares da biomassa.
Texto: Vivian Chies (MTb 42.643/SP)





